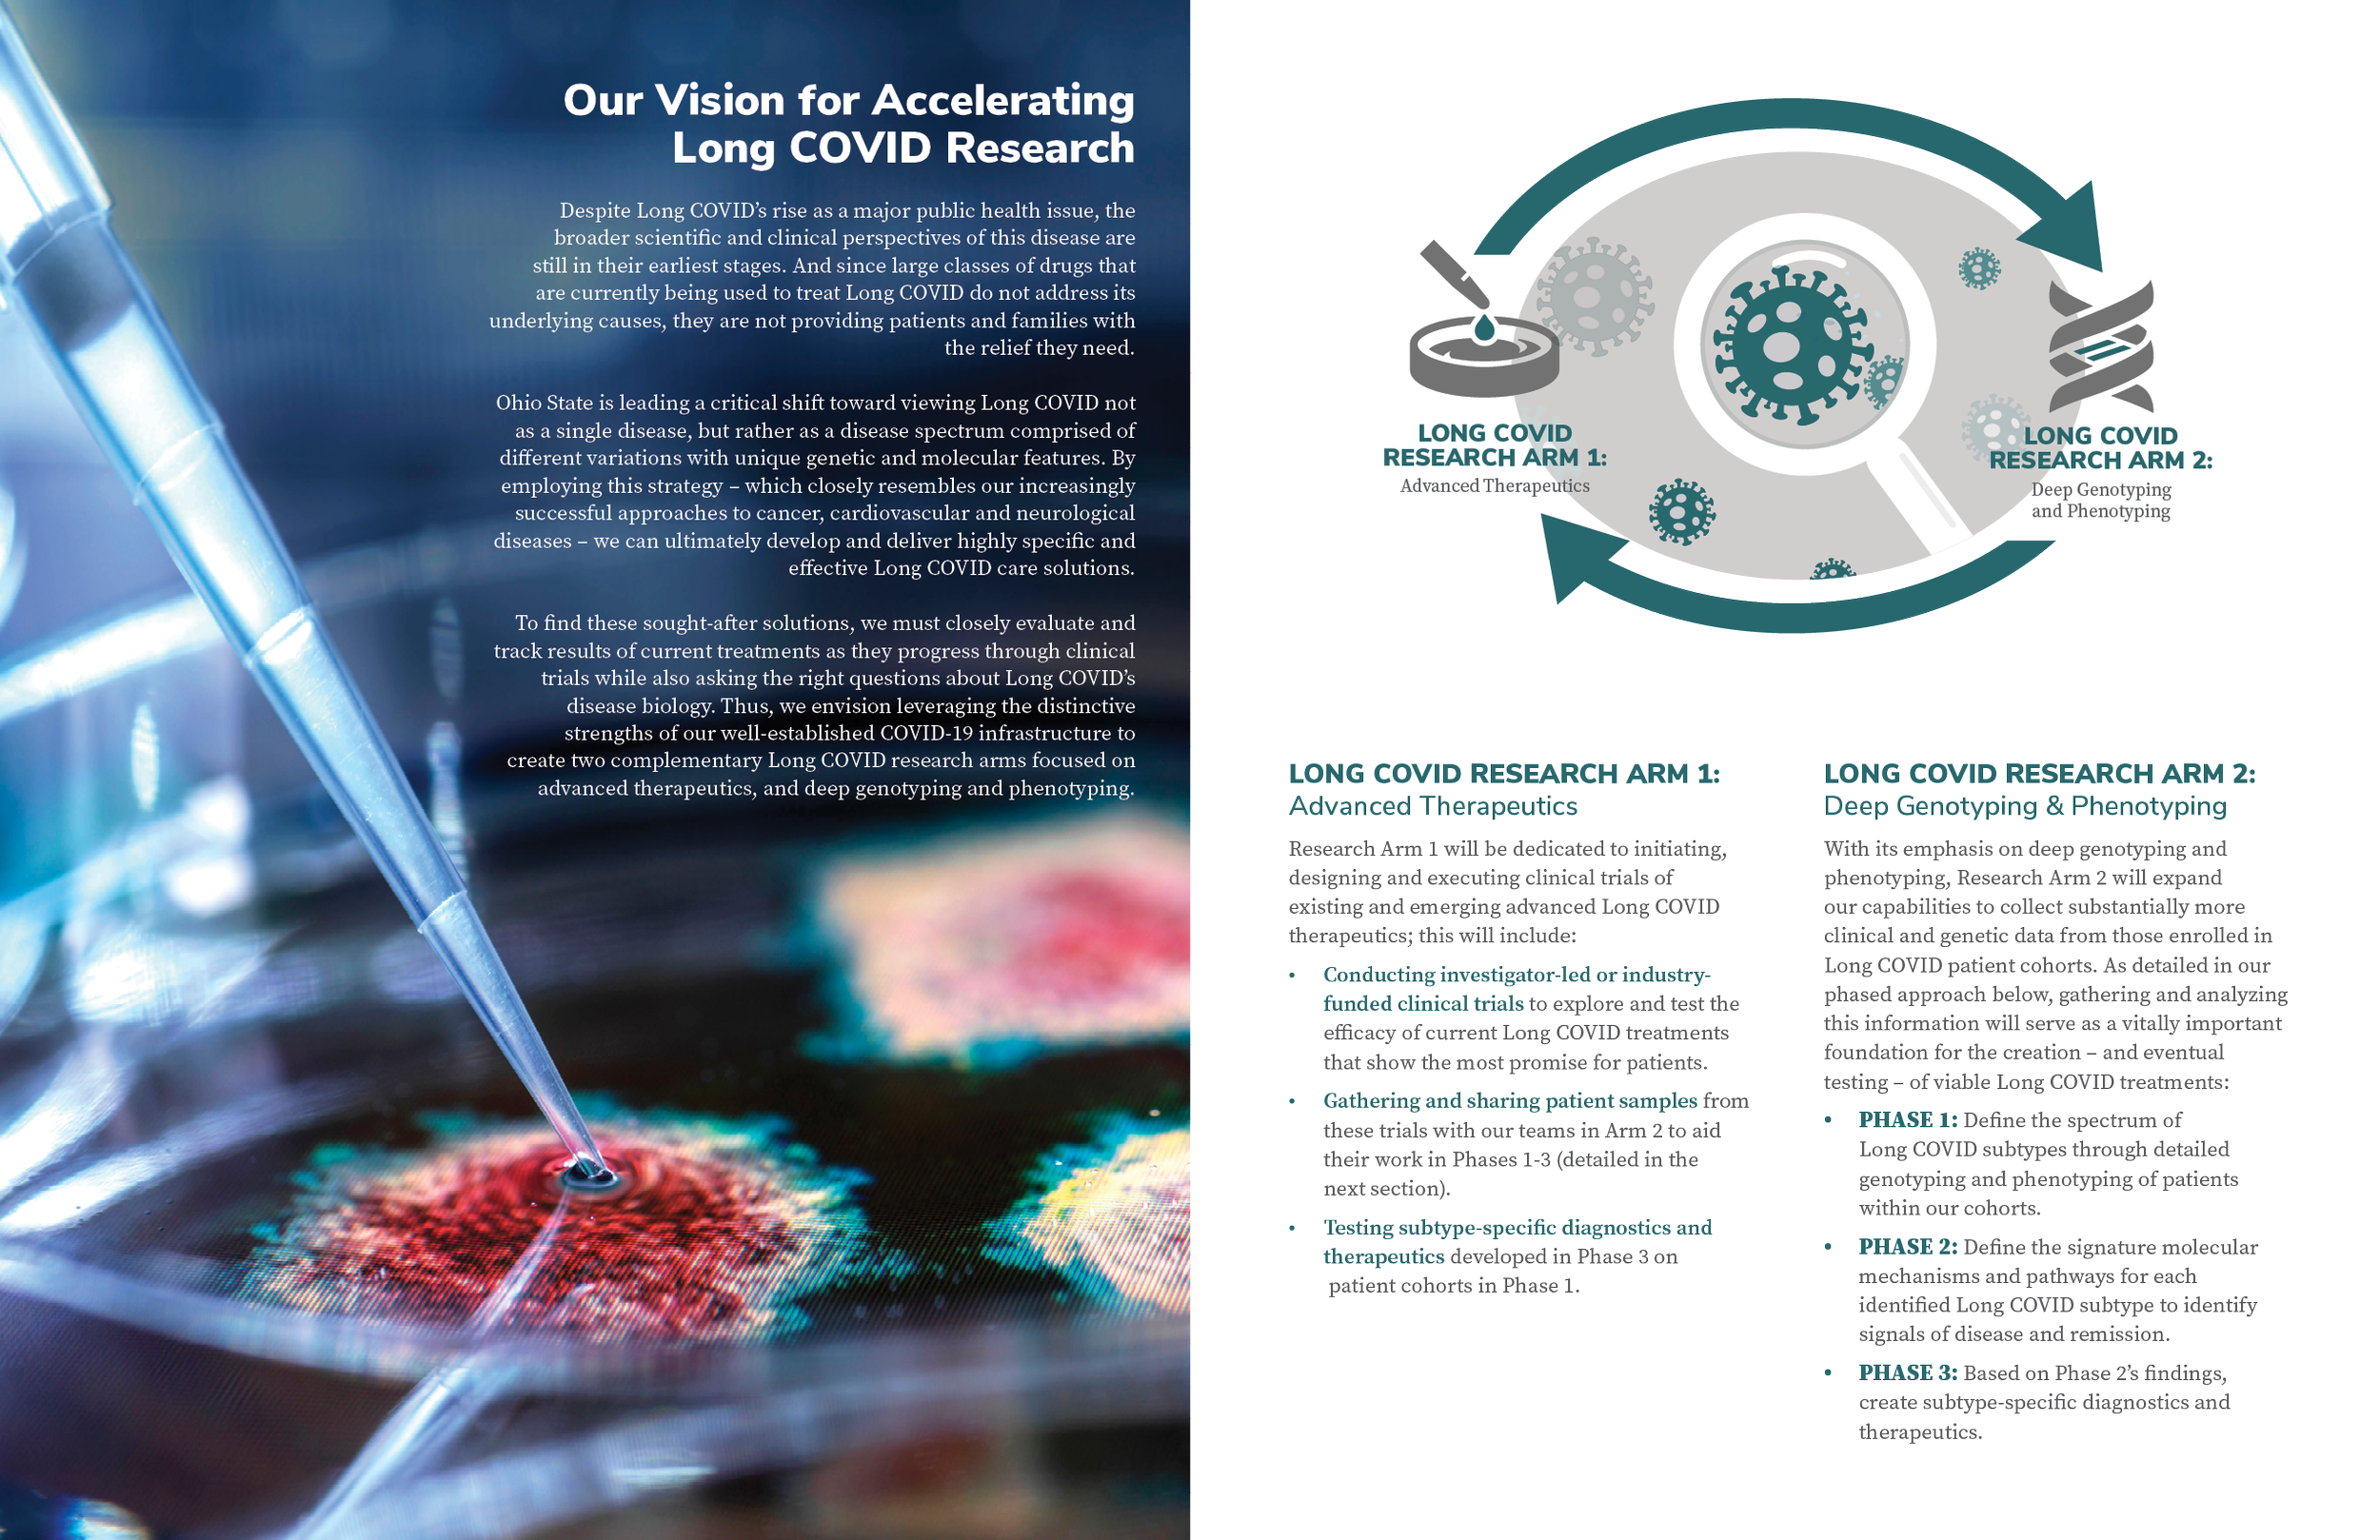
ADV_PG_Siemer3.png

How Firm thy friendship…
take a look at the creative impact i was able to make at the ohio state university
Beyond the Walls



The mangurian foundation | 2022 impact report
Timashev Family Music Building Dedication Book
The Timashev Institute for Software Innovation presentation
Women and Philanthropy





















Monda International Experience Scholarships
2022 Brutus Reading Challenge | Kids & Adult Versions













Principal Gift Proposal
Alumni Association Digital Downloads